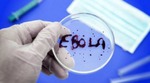

| ← Октябрь 2014 → | ||||||
|
1
|
3
|
4
|
5
|
|||
|---|---|---|---|---|---|---|
|
6
|
7
|
8
|
10
|
11
|
12
|
|
|
13
|
14
|
15
|
17
|
18
|
19
|
|
|
20
|
21
|
22
|
24
|
25
|
26
|
|
|
27
|
28
|
29
|
31
|
|||
За последние 60 дней 1 выпусков (1 раз в 2 месяца)
Сайт рассылки:
http://www.myjane.ru/
Открыта:
01-02-2005
Статистика
+1 за неделю


 ВКонтакте
ВКонтакте в Одноклассниках
в Одноклассниках в Facebook
в Facebook